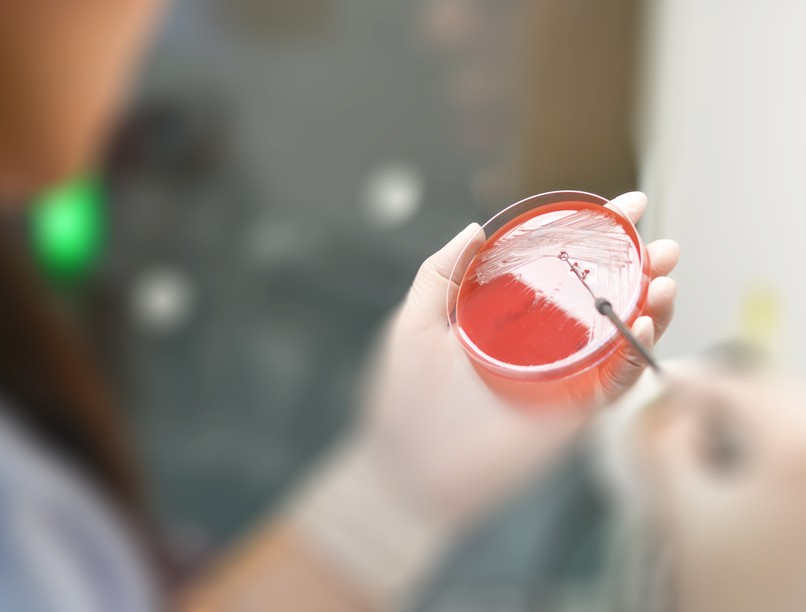
antiotikum, rezisztens, antibiotikum-rezisztancia, fabimicin

Aggodalomra ad okot, hogy egyre kevésbé hatásosak az antibiotikumok.
Évente közel 5 millió haláleset történik világszerte amiatt, hogy a fertőzéseket okozó baktériumok nem reagálnak kellőképpen, azaz rezisztensek az ellenük alkalmazott antibiotikumokra. Odafigyelést és elismerést érdemel(ne) minden olyan kutatás és fejlesztés, ami olyan antibiotikumokat alkotna meg, amik a - korábban - rezisztens baktériumok ellen is hatásosak lennének. Nemrégiben egy olyan vegyület fejlesztéséről számoltak be a kutatók, ami több, mint 300 baktérium ellen is hatásos lehet.
Antibiotikum-rezisztencia: több millió ember halálát okozza évente
A baktériumok okozta fertőzésre sokan csupán legyintenek. „Sebaj, ott vannak az antibiotikumok, és majd megoldódik a probléma”. Mindez téves megközelítés.
Világszerte évente 1,2 millió ember veszíti életét közvetlenül antibiotikum-rezisztencia miatt, míg éves szinten 4,95 millió ember halála hozható közvetlen vagy közvetett módon kapcsolatba az antibiotikum-rezisztenciával. A fertőzések egy része kórházi fertőzés, másik része otthon szerzett/kezelt fertőzés, amire nincs hatásos gyógyszer.
Az összehasonlítás kedvéért: HIV/AIDS következtében évente 680000 fő hal meg világszerte, maláriában 627000 ember veszíti életét minden évben. Az új típusú koronavírus fertőzés (Covid-19) következtében eddig (2022. augusztus), közel 3 év alatt, körülbelül 6,4 millió fő veszítette életét világszerte.
Ne higgyük azt, hogy az antibiotikum-rezisztencia problémája a fejlődő országokra korlátozódik, és például Európát nem érinti! Bár tény, hogy az elmaradott országokban markánsabban, közel kétszer olyan nagy gyakorisággal lép fel a jelenség.
Az antibiotikumok szedése növelheti a vastagbélrák esélyét?
Nem jut be az antibiotikum a baktériumokba vagy kipumpálódik
Azok a baktériumok elleni gyógyszerek, amik korábban hatásosnak bizonyultak, ma már gyakran kevesek. A helyzet világszerte ugyanaz: a baktériumok „kicselezték” az őket elpusztító antibiotikumokat, és nem engedik, hogy azok átjussanak a sejtjüket határoló membránon, vagy ha mégis átjutnak, akkor speciális pumpák segítségével a baktériumok kipumpálják magukból az antibiotikumokat.
A kórházak az rezisztens baktériumok „melegágyai”. Könnyen mindennapivá válhat tehát az a helyzet, miszerint „a műtét sikerült, de a beteget elveszítettük”.
Ki a hibás azért, hogy nincsenek „ütőképes” antibiotikumaink?
Lehet hibáztatni
- a kutatókat és a gyártókat, hogy nem sikerült ideáig tartósan hatásos szert alkotniuk,
- a betegeket, akik nem az orvos előírásai szerint szedik a felírt antibiotikumot és ezzel fokozzák a rezisztencia fellépésének a kockázatát,
- a Covid-19 pandémiát, ami jelentősen fokozta az antibiotikum-használatot az elmúlt időszakban, és ezzel is gerjesztette a rezisztenciát,
- a kormányzati és egészségügyi döntéshozó szerveket, miszerint a közelmúltban nem kapott nagyobb támogatást az antibiotikum-fejlesztés…
Mindez hiába. Tény, hogy a rezisztens baktériumok okozta fertőzések száma egyre nő, és egyre gyakrabban szembesülünk azzal, hogy az orvosok gyógyító eszköztára véges, és bizonyos fertőzésekre (már) nincs orvosság.
Vannak reményt nyújtó kutatások
Különösen jó hírnek számít az, hogy USA-beli kutatók nemrégiben egy olyan új molekuláról, a fabimicinről számoltak be, ami több, mint 300 baktérium ellen is hatásos lehet. Ez esetben olyan, Gram-negatív baktériumokról van szó, amik vastag sejtfalukra és az abban található kifelé pumpáló csatornákra visszavezethetően korábban ellenálltak a különféle antibiotikumok támadásának. A fabimicin esetén mindez megváltozni látszik.
A kutatók találékonyságának köszönhetően a fabimicin egy olyan molekula, ami masszívan áttöri magát a bakteriális sejtmembránokon, és nem engedi, hogy a baktériumok kipumpálják magukból. Azaz, a fabimicin azokkal a baktériumokkal szemben is képes pusztítólag fellépni, amikkel a korábban alkalmazott antibiotikumok már „nem tudtak mit kezdeni”.
Bélflóra: ennyi időbe telik, mire az emésztése kiheveri az antibiotikumkúrát
Korai az öröm az új gyógyszer kapcsán?
Le kell azonban lohasztani a kedélyeket. Egyelőre még csak Petri-csészés laboratóriumi vizsgálatok és állatkísérletek támasztják alá azt, hogy a fabimicin ígéretes és hatásos szer. A közeljövőben történhetnek meg a humán vizsgálatok, és akár éveket is igénybe vehet, mire a patikák polcain megjelenik majd a fabimicin-tartalmú gyógyszer.
Addig is lényeges, hogy mi is – betegként – mindent megtegyünk az antibiotikumokkal szembeni rezisztencia letörése érdekében.
- Lényeges, hogy vírusos vagy gombás fertőzéseknél ne „követeljük” az orvostól antibiotikum felírását! Ezekben az esetben az antibiotikum egyébként is hatástalan lenne.
- Minden esetben az orvosi/gyógyszerészi utasításoknak megfelelően szedjük az antibiotikumokat!
- Önhatalmúlag sose kezdjünk el antibiotikumot szedni, akkor sem, ha egy korábbi betegségből még maradt otthon pár tabletta!
- A be nem szedett antibiotikumokat ne dobjuk a szemétbe, ne húzzuk le a toaletten, hanem vigyük vissza a patikába, ahol gondoskodnak azok szakszerű megsemmisítéséről!
Dr. Budai Marianna PhD.
szakgyógyszerész
Kövesse az Egészségkalauz cikkeit a Google Hírek-ben, a Facebook-on, az Instagramon vagy a X-en,Tiktok-on is!